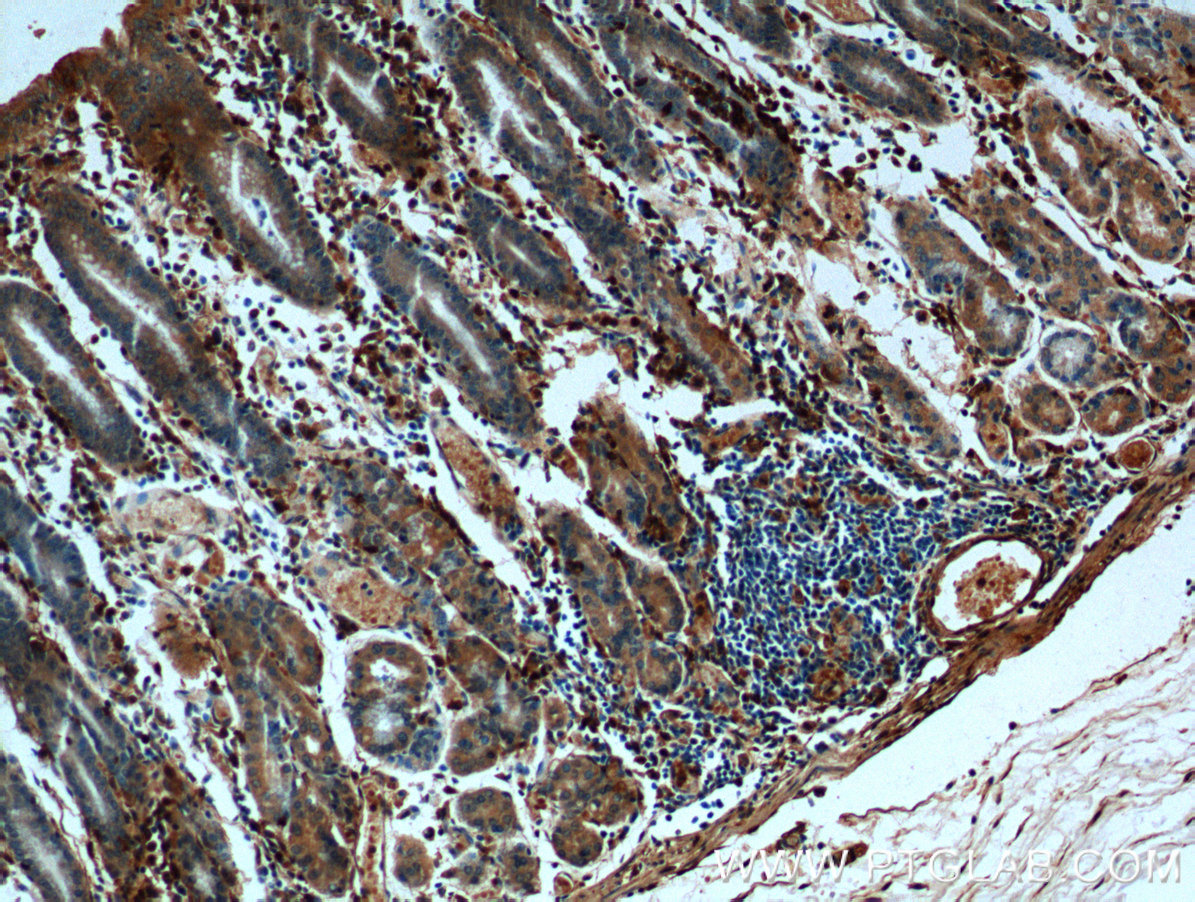

验证数据展示
经过测试的应用
| Positive WB detected in | A549 cells, HeLa cells, A431 cells, NIH/3T3 cells, 4T1 cells, HCT 116 cells, Jurkat cells, K-562 cells, HepG2 cells |
| Positive IHC detected in | human stomach tissue, human liver tissue, human pancreas tissue, mouse liver tissue Note: suggested antigen retrieval with TE buffer pH 9.0; (*) Alternatively, antigen retrieval may be performed with citrate buffer pH 6.0 |
| Positive IF/ICC detected in | A549 cells |
| Positive FC (Intra) detected in | K-562 cells |
推荐稀释比
| 应用 | 推荐稀释比 |
|---|---|
| Western Blot (WB) | WB : 1:5000-1:50000 |
| Immunohistochemistry (IHC) | IHC : 1:50-1:500 |
| Immunofluorescence (IF)/ICC | IF/ICC : 1:400-1:1600 |
| Flow Cytometry (FC) (INTRA) | FC (INTRA) : 0.80 ug per 10^6 cells in a 100 µl suspension |
| It is recommended that this reagent should be titrated in each testing system to obtain optimal results. | |
| Sample-dependent, Check data in validation data gallery. | |
产品信息
66344-1-Ig targets Annexin A1 in WB, IHC, IF/ICC, FC (Intra), ELISA applications and shows reactivity with human, mouse, rat samples.
| 经测试应用 | WB, IHC, IF/ICC, FC (Intra), ELISA Application Description |
| 文献引用应用 | WB, IHC, IF |
| 经测试反应性 | human, mouse, rat |
| 文献引用反应性 | human, mouse |
| 免疫原 |
CatNo: Ag17273 Product name: Recombinant human ANXA1 protein Source: e coli.-derived, PGEX-4T Tag: GST Domain: 1-346 aa of BC001275 Sequence: MAMVSEFLKQAWFIENEEQEYVQTVKSSKGGPGSAVSPYPTFNPSSDVAALHKAIMVKGVDEATIIDILTKRNNAQRQQIKAAYLQETGKPLDETLKKALTGHLEEVVLALLKTPAQFDADELRAAMKGLGTDEDTLIEILASRTNKEIRDINRVYREELKRDLAKDITSDTSGDFRNALLSLAKGDRSEDFGVNEDLADSDARALYEAGERRKGTDVNVFNTILTTRSYPQLRRVFQKYTKYSKHDMNKVLDLELKGDIEKCLTAIVKCATSKPAFFAEKLHQAMKGVGTRHKALIRIMVSRSEIDMNDIKAFYQKMYGISLCQAILDETKGDYEKILVALCGGN 种属同源性预测 |
| 宿主/亚型 | Mouse / IgG1 |
| 抗体类别 | Monoclonal |
| 产品类型 | Antibody |
| 全称 | annexin A1 |
| 别名 | ANXA1, 1E1B7, Annexin 1, Annexin Ac2-26, Annexin I |
| 计算分子量 | 346 aa, 39 kDa |
| 观测分子量 | 35 kDa |
| GenBank蛋白编号 | BC001275 |
| 基因名称 | Annexin A1 |
| Gene ID (NCBI) | 301 |
| RRID | AB_2881724 |
| 偶联类型 | Unconjugated |
| 形式 | Liquid |
| 纯化方式 | Protein A purification |
| UNIPROT ID | P04083 |
| 储存缓冲液 | PBS with 0.02% sodium azide and 50% glycerol, pH 7.3. |
| 储存条件 | Store at -20°C. Stable for one year after shipment. Aliquoting is unnecessary for -20oC storage. |
背景介绍
ANXA1, also named as ANX1, LPC1 and p35, belongs to the annexin family. It is a member of the annexin family of Ca2+-binding and phospholipidbinding proteins, and it is particularly abundant in various populations of peripheral blood leukocytes. ANXA1 regulates phospholipase A2 activity. It seems to bind from two to four calcium ions with high affinity. ANXA1 is a pleiotrophic protein produced by many cell types including peripheral blood leucocytes.
实验方案
| Product Specific Protocols | |
|---|---|
| FC protocol for Annexin A1 antibody 66344-1-Ig | Download protocol |
| IF protocol for Annexin A1 antibody 66344-1-Ig | Download protocol |
| IHC protocol for Annexin A1 antibody 66344-1-Ig | Download protocol |
| WB protocol for Annexin A1 antibody 66344-1-Ig | Download protocol |
| Standard Protocols | |
|---|---|
| Click here to view our Standard Protocols |
发表文章
| Species | Application | Title |
|---|---|---|
Adv Sci (Weinh) M2 Macrophage-Derived Extracellular Vesicles Reprogram Immature Neutrophils into Anxa1hi Neutrophils to Enhance Inflamed Bone Regeneration | ||
Adv Sci (Weinh) Cancer Cell-Derived Large Extracellular Vesicles Promote Venous Thromboembolism by Activating NETosis Through Delivering CYBA | ||
Matrix Biol Proteome-wide and matrisome-specific atlas of the human ovary computes fertility biomarker candidates and open the way for precision oncofertility. | ||
J Mater Chem B Magnetic hyperthermia induces effective and genuine immunogenic tumor cell death with respect to exogenous heating | ||
Nat Commun Annexin A1 is a polarity cue that directs mitotic spindle orientation during mammalian epithelial morphogenesis | ||
J Proteome Res Effect of Tamoxifen on Proteome Expression during In Vitro Myogenesis in Murine Skeletal Muscle C2C12 Cells |